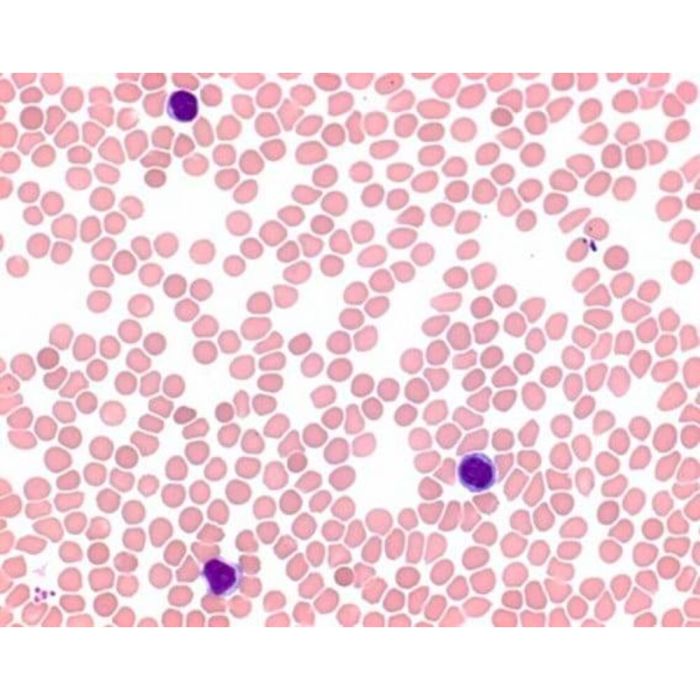
main product photo

May-Grünwalds Eosin- Methylenblaulösung modifiziert für die Mikroskopie
May-Grünwalds Eosin- Methylenblaulösung modifiziert für die Mikroskopie
Artikelnummer
1.01424.0100
Mindestbestellmenge 1, oder ein Vielfaches davon
| Verpackungseinheit | 100 ml |
|---|---|
| GTIN | 4022536020761 |
| Hersteller | Merck Life Science |
| Medizinprodukt | nein |
| In-vitro-Diagnostika | Klasse A |
| Lagertemperatur | 15 - 25°C |
| Zolltarifnummer | 32129000 |
| Qualität | für die Mikroskopie |
Wenn Sie einen Download vermissen, kontaktieren Sie uns bitte über info@diagonal.de.

| Produktbereich | Art | Bezeichnung | Sprache | Dateityp | Größe |
|---|
| eClass 13.0 | 30194106 |
|---|---|
| eClass 15.0 | 30194106 |
| eClass 5.1.4 | 30194106 |
| eClass 7.1 | 30194106 |